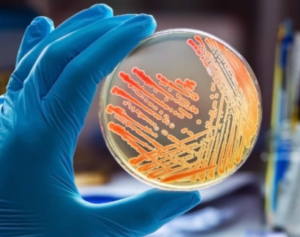

ইভিএম নিউজ ব্যুরো, ৩ এপ্রিলঃ এবার গাছের সংক্রমণ দেখা দিল মানবদেহে। আর তার হদিশ পাওয়া গেল খাস কলকাতার বুকে। উত্তর ২৪ পরগণার এক ব্যক্তির শরীরে ধরা পড়ল এই উদ্ভীদজাত ছত্রাকঘটিত সংক্রমণ। ওই ব্যক্তির বয়স ৬০ বছর। পেশায় উদ্ভিদ-ছত্রাক বিশেষজ্ঞ। এই ধরনের সংক্রমণের নজির গোটা বিশ্বেই এই প্রথম। আর এই বিষয়টি প্রথম প্রকাশ করা হয় ‘মেডিক্যাল মাইকোলজি কেস রিপোর্টস’জার্নালে। আর তথ্যটি সামনে আসতেই স্তম্ভিত গোটা মেডিক্যাল জগত।
জানা গিয়েছে, ছত্রাক সংক্রামণটির নাম, ‘সিলভার লিফ’। যার ফলে গাছের পাতার রঙ আস্তে আস্তে রুপোলী হয়ে যায়। সাধারণত গোলাপ প্রজাতির গাছে এই সংক্রামণটি বেশি লক্ষ্য করা যায়।
উল্লেখ্য, ২০১৯ এ প্রথম ঐ ব্যক্তির শরীরে সংক্রমণ চিহ্নিত করা গিয়েছিল অ্যাপোলো হাসপাতালে। কিন্তু বোঝা যায়নি কি থেকে সংক্রমণ হয়েছে। মূলত শ্বাসকষ্ট, বদলে যাওয়া কণ্ঠস্বর, কাশি, ফ্যারিঙ্গাসে প্রদাহ, ক্লান্তি, খাবার গেলার সমস্যা ইত্যাদি উপসর্গ নিয়ে হাসপাতালে গিয়েছিলেন ঐ ব্যক্তি। সম্প্রতি গত প্রায় তিন মাস ধরে ভুগছিলেন তিনি।পরে গোটা বিষয়টি গবেশনাপত্রের আকারে একটি জার্নালে তুলে ধরেন অ্যাপোলোর দুই মাইক্রোবাইয়োলজি বিশেষজ্ঞ চিকিৎসক সোমা দত্ত এবং উজ্জ্বয়িনী রায়।
এই বিষয়ে তাঁরা বলেন, ওই ব্যক্তির সিটি স্ক্যান করে ধরা পড়ে তার শ্বাসনালীর পাশে একটি ঘা (প্যারা-ট্র্যাকিয়াল অ্যাবসেস) রয়েছে। প্রথমদিকে স্বাস্থ্যপরীক্ষায় নেপথ্যে থাকা জীবাণুকে চিহ্নিত করা যাচ্ছিল না। পরে জিন বিশ্লেষণে জানা যায়, সংক্রমণটা আসলে কন্ড্রোস্টেরিয়াম পারপিউরিয়াম ছত্রাক। বিষয়টি সামনে আসতেই অবাক হয়ে যান চিকিৎসকরা। কারণ, এই সংক্রমণটি কেবলমাত্র গাছের শরীরে দেখা যেত। এবং উদ্ভিদের জন্য যা প্রাণঘাতী।
এই প্রসঙ্গে, গবেষকরা জানিয়েছে, দীর্ঘ দিন ধরে প্ল্যান্ট মাইকোলজি নিয়ে কাজ করেছেন ওই প্রৌঢ়। আশা করা যায় সেখান থেকেই এই সংক্রমণ। ডায়াবেটিস, এইচআইভি কিংবা কিডনি বা অন্য কোনও অঙ্গের পুরোনা অসুখ ও শরীরে কোথাও কোনও আঘাত না-থাকার কারণে তিন মাসেই সম্পূর্ণ সেরে ওঠেন ওই ৬১ বছরের প্রৌঢ়।(EVM News)

















